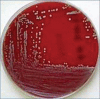

Epidemiology and clinico-investigative study of organisms causing vaginal discharge
- PMID: 28442807
- PMCID: PMC5389219
- DOI: 10.4103/0253-7184.203433
Epidemiology and clinico-investigative study of organisms causing vaginal discharge
Abstract
Background: Abnormal vaginal discharge is a common clinical problem in reproductive age group. It is the second most common problem after abnormal uterine bleeding. It is a neglected health problem, most commonly caused due to vulvovaginal candidiasis, trichomoniasis, and bacterial vaginosis (BV).
Objectives: The present study was conducted to determine the prevalence of common organisms causing vaginal discharge and also to know the variety of clinical presentation.
Materials and methods: A cross-sectional descriptive study was conducted in the Skin and STD Outpatient Department of Vinayaka Mission Kirupananda Variyar Medical College Hospital, Salem, who presented with abnormal vaginal discharge between September 2012 and September 2014. A total of 100 women in the reproductive age group who had symptoms of vaginitis were examined. Data were coded and analyzed.
Results: Out of the 100 patients examined, 77 (77%) cases were organism positive. Among the positive cases, BV (27%) was the most common microbiological cause of abnormal vaginal discharge, followed by trichomoniasis (25%), vaginal candidiasis (22%), combined infection (Candida and BV) (3%), and nonspecific cases (23%).
Conclusion: Out of 100 cases, few cases showed discordance between clinical and laboratory diagnosis. This discordance can be due to pitfalls in identifying the causative agent clinically or obscuring of the findings due to improper treatment received for other ailments. Thus, clinico-investigative correlation is more important than other clinical findings alone.
Keywords: Bacterial vaginosis; candidiasis; nonspecific vaginitis; trichomoniasis.
Conflict of interest statement
There are no conflicts of interest.
Figures

Similar articles
-
A Cross-Sectional Clinical Investigation of Organisms Causing Vaginal Discharge in Patients in Rural Tamil Nadu, India.Cureus. 2023 Jan 19;15(1):e33979. doi: 10.7759/cureus.33979. eCollection 2023 Jan. Cureus. 2023. PMID: 36811046 Free PMC article.
-
Risk assessment, symptoms, and signs as predictors of vulvovaginal and cervical infections in an urban US STD clinic: implications for use of STD algorithms.Sex Transm Infect. 1998 Jun;74 Suppl 1:S59-76. Sex Transm Infect. 1998. PMID: 10023355
-
Evaluation of two clinical protocols for the management of women with vaginal discharge in southern Thailand.Sex Transm Infect. 1998 Jun;74(3):194-201. doi: 10.1136/sti.74.3.194. Sex Transm Infect. 1998. PMID: 9849555 Free PMC article. Clinical Trial.
-
Evaluation of vaginal complaints.JAMA. 2004 Mar 17;291(11):1368-79. doi: 10.1001/jama.291.11.1368. JAMA. 2004. PMID: 15026404 Review.
-
Vaginitis.Am Fam Physician. 2011 Apr 1;83(7):807-15. Am Fam Physician. 2011. PMID: 21524046 Review.
Cited by
-
Vaginal Discharge that Persisted for 6 Years.Indian Dermatol Online J. 2024 Feb 13;15(4):670-672. doi: 10.4103/idoj.idoj_442_23. eCollection 2024 Jul-Aug. Indian Dermatol Online J. 2024. PMID: 39050084 Free PMC article. No abstract available.
-
Efficacy of Acacia nilotica Linn. Pod's Sitz Bath plus Vaginal Pessary in Syndromic Management of Abnormal Vaginal Discharge: A Randomized Controlled Trial.Evid Based Complement Alternat Med. 2022 May 25;2022:5769555. doi: 10.1155/2022/5769555. eCollection 2022. Evid Based Complement Alternat Med. 2022. PMID: 35664940 Free PMC article.
-
Recent Advances in Presentation, Diagnosis and Treatment for Mixed Vaginitis.Front Cell Infect Microbiol. 2021 Nov 2;11:759795. doi: 10.3389/fcimb.2021.759795. eCollection 2021. Front Cell Infect Microbiol. 2021. PMID: 34796129 Free PMC article. Review.
-
Patient characteristics and factors contributing to recurrence of bacterial vaginosis presented in primary care.Fam Pract. 2023 Dec 22;40(5-6):655-661. doi: 10.1093/fampra/cmad005. Fam Pract. 2023. PMID: 36708208 Free PMC article.
-
Clinicoetiological study on vaginal discharge among sexually active women attending a tertiary center in North Kerala, India.Indian J Sex Transm Dis AIDS. 2023 Jan-Jun;44(1):1-5. doi: 10.4103/ijstd.ijstd_65_21. Epub 2022 Dec 9. Indian J Sex Transm Dis AIDS. 2023. PMID: 37457531 Free PMC article.
References
-
- Yudkin G. Vaginal discharge. In: McPherson AA, editor. Women's Problems in General Practice. 2nd ed. Oxford: Oxford University Press; 1988.
-
- Fox KK, Behets FM. Vaginal discharge. How to pinpoint the cause. Postgrad Med. 1995;98:87. - PubMed
-
- Cullins VA, Dominguez L, Guberski T, Secor RM, Wysocki SJ. Treating vaginitis. Nurse Pract. 1999;24:46, 49. - PubMed
LinkOut - more resources
Full Text Sources
Other Literature Sources
Research Materials